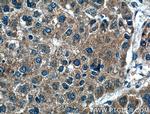
FGF3 Antibody in Immunohistochemistry (Paraffin) (IHC (P))

Search
Proteintech
FGF3 Polyclonal Antibody
{{$productOrderCtrl.translations['antibody.pdp.commerceCard.promotion.promotions']}}
{{$productOrderCtrl.translations['antibody.pdp.commerceCard.promotion.viewpromo']}}
{{$productOrderCtrl.translations['antibody.pdp.commerceCard.promotion.promocode']}}: {{promo.promoCode}} {{promo.promoTitle}} {{promo.promoDescription}}. {{$productOrderCtrl.translations['antibody.pdp.commerceCard.promotion.learnmore']}}
产品信息
27100-1-AP
种属反应
宿主/亚型
分类
类型
抗原
偶联物
形式
浓度
规格
纯化类型
保存液
内含物
保存条件
运输条件
产品详细信息
Immunogen sequence: QKSSLFLPR VLDHRDHEMV RQLQSGLPRP PGKGVQPRRR RQKQSPDNLE PSHVQASRLG SQLEASAH (173-239 aa encoded by BC113739)
靶标信息
Fibroblast growth factors (FGFs) can stimulate the proliferation of mesenchymal, epithelial and neuroectodermal cells. FGF3 belongs to the heparin binding growth factors family. Members of the family include Acidic FGF (also known as aFGF or FGF 1), basic FGF (bFGF or FGF 2), FGF 3 (also known as Int2) and FGF 4 (also known as hst or Kaposi FGF). FGF 4 was first revealed to be an oncoprotein in Kaposi's sarcoma cells. Other family members include FGF 5, FGF 6, FGF 7 (keratinocyte growth factor, KGF), FGF 8 (AIGF), FGF 9 (GAF) and FGF 10. FGF3 is activated by proviral insertion of mouse mammary tumor virus (MMTV). FGF3 is responsible for most of breast malignancies.
仅用于科研。不用于诊断过程。未经明确授权不得转售。
篇参考文献 (0)
生物信息学
蛋白别名: FGF; FGF-3; Fibroblast growth factor; Fibroblast growth factor 3; fibroblast growth factor 3 (murine mammary tumor virus integration site (v-int-2) oncogene homolog); HBGF-3; Heparin-binding growth factor 3; INT-2 proto-oncogene protein; murine mammary tumor virus integration site 2, mouse; oncogene INT2; Proto-oncogene Int-2; V-INT2 murine mammary tumor virus integration site oncogene homolog
基因别名: FGF3; HBGF-3; INT2
UniProt ID: (Human) P11487
Entrez Gene ID: (Human) 2248